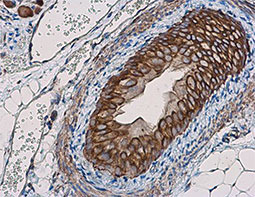
TNF alpha antibody

![]() |
|
随着对癌细胞如何逃脱免疫破坏的了解的增加,研究人员已大大推动了癌症免疫疗法的发展,特别是描述包括PD-1和CTLA-4途径在内的不同免疫检查点,如何起到增强减弱T细胞抗肿瘤活性的研究揭示了干预疗法的新机会,研究人员在抑制这些检查点以释放T细胞的杀伤潜力方面取得了可喜的进步,鉴于放疗和化学疗法也都可以动员抗肿瘤T细胞,令人兴奋的是,可以将检查点抑制和其他免疫调节方法与常规方法相结合,以使许多恶性肿瘤的临床疗效最大化。 |
GeneTex为您的研究提供了出色的PD-L1抗体
|
| PD-L1 antibody (GTX104763) | |||||
|
|
|||||
|
|
|
Click here to view the full list of antibodies for the study of immune checkpoints
| Highlighted Products | |||||
|
|||||
|
|
|
|
|
|
|
|
|
|
|
|
|
|
|





![CTLA4 antibody [IHC004]](/upload/media/research/Cancer/Cancer_Immune_Checkpoints/Cancer-Immune-Checkpoints_05.jpg)
![CD4 antibody [GK1.5]](/upload/media/research/Cancer/Cancer_Immune_Checkpoints/Cancer-Immune-Checkpoints_06.jpg)

![CD80 antibody [2B11]](/upload/media/research/Cancer/Cancer_Immune_Checkpoints/Cancer-Immune-Checkpoints_08.jpg)
![CD86 antibody [24F]](/upload/media/research/Cancer/Cancer_Immune_Checkpoints/Cancer-Immune-Checkpoints_10.jpg)
![4-1BB / CD137 antibody [17B5] (FITC)](/upload/media/research/Cancer/Cancer_Immune_Checkpoints/Cancer-Immune-Checkpoints_11.jpg)
![B7-H3 / CD276 antibody [MIH42] (PE)](/upload/media/research/Cancer/Cancer_Immune_Checkpoints/Cancer-Immune-Checkpoints_12.jpg)
![TIM-3 antibody [RMT3-23] (FITC)](/upload/media/research/Cancer/Cancer_Immune_Checkpoints/Cancer-Immune-Checkpoints_13.jpg)
![LAG3 antibody [C9B7W] (Low endotoxin, azide free)](/upload/media/research/Cancer/Cancer_Immune_Checkpoints/Cancer-Immune-Checkpoints_14.jpg)
](/upload/media/research/Cancer/Cancer_Immune_Checkpoints/GTX634652.jpg)


